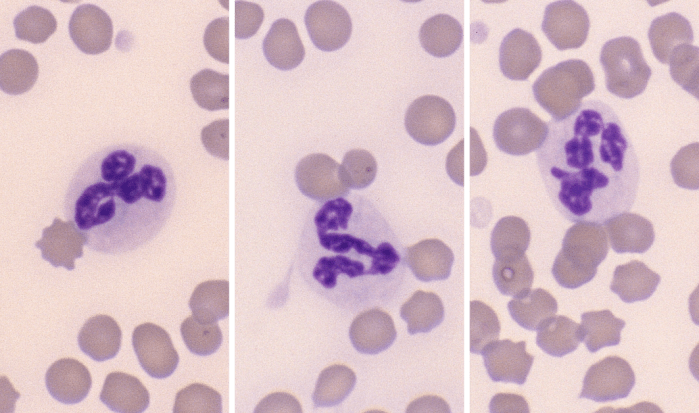
Neutrophils 4-6 (Equine 1-3) ARROWS
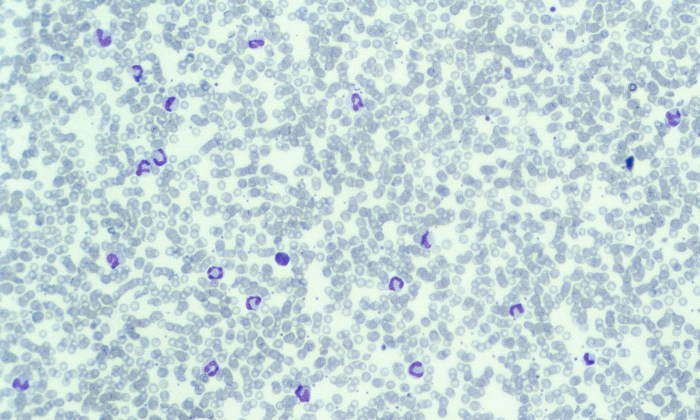
Neutrophils 15 (Canine 6 - Neutrophilia)

Neutrophils

Also called: mature neutrophils, segmented neutrophils (segs), polymorphonuclear cells (PMN)
Morphology: granulocyte with an indented (segmented) nucleus and white or pale pink cytoplasm. Canine and bovine neutrophils may contain small pink cytoplasmic granules, while feline and equine neutrophils typically lack visible granules.
Look alike: other granulocytes (eosinophils, basophils)
Commonly seen with: bands (left shift), toxic change
Clinical relevance: neutrophils are the most common leukocytes in peripheral blood of healthy animals, except cattle in which lymphocytes predominate). Neutrophila (↑ neutrophils in peripheral blood) is most commonly associated with acute stress (epinephrine release), corticosteroids, inflammation, and bacterial infection.